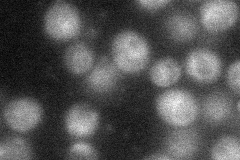
YGL192W
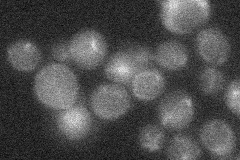
YGL192W
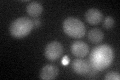
YGL192W
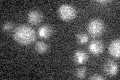
YGL192W

View description
Probable mRNA N6-adenosine methyltransferase required for entry into meiosis; transcribed in diploid cells; haploids repress IME4 transcription via production of antisense IME4 transcripts; antisense transcription is repressed in diploids
Localization:
Intensity:
Fold change:
Significance:
-
C’ GFP library in SD

below threshold18.3 -
N' NOP1pr-GFP in SD
cytosol,punctate32.5689 -
N' TEF2pr-mCherry in SD

below threshold6.93694 -
N' NATIVEpr-GFP in SD
below threshold19.0978 -
N' TEF2pr-VC and Cyto-VN in SD

#N/A0 -
C’ GFP library in SD+DTT
cytosol16.680.91No -
C’ GFP library in SD+H2O2

cytosol17.810.97No -
C’ GFP library in Starvation Media
cytosol15.50.84No -
C’ GFP library on the background of Pup2-DaMP

below threshold -
C’ GFP library on the background of CCT mutant

below threshold18.67221.01997No
